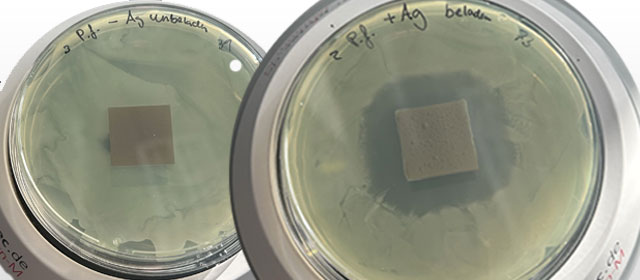
Projektschritte

Why do we need a new solution?
Implants effectively stabilize injured bones or replace bone segments. However, painful infections can occur, complicating or even preventing healing. The risk is higher in heavily contaminated wounds, which are especially common in war zones where many bone injuries need treatment. Currently, clinics in Ukraine are struggling with numerous poorly healing bone injuries that can lead to permanent damage. This is an issue that researchers at the Fraunhofer Institute for Manufacturing Technology and Advanced Materials IFAM in Bremen aim to address with a novel technology.